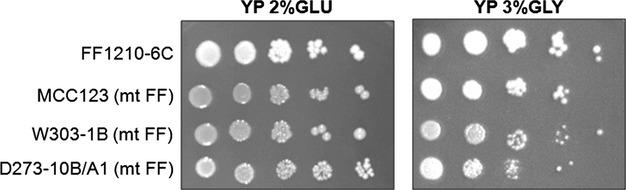

菌株特异性核遗传背景对酿酒酵母中线粒体相关表型有不同影响。
Strain-specific nuclear genetic background differentially affects mitochondria-related phenotypes in Saccharomyces cerevisiae.
作者信息
Montanari Arianna, Francisci Silvia, Fazzi D'Orsi Mario, Bianchi Michele Maria
机构信息
Department of Biology and Biotechnologies "C. Darwin", Sapienza University of Rome, Piazzale A. Moro 5, Rome, 00185, Italy; Pasteur Institute-Cenci Bolognetti Foundation, Sapienza University of Rome, Piazzale A. Moro 5, Rome, 00185, Italy.
出版信息
Microbiologyopen. 2014 Jun;3(3):288-98. doi: 10.1002/mbo3.167. Epub 2014 Apr 2.
In the course of our studies on mitochondrial defects, we have observed important phenotypic variations in Saccharomyces cerevisiae strains suggesting that a better characterization of the genetic variability will be essential to define the relationship between the mitochondrial efficiency and the presence of different nuclear backgrounds. In this manuscript, we have extended the study of such relations by comparing phenotypic assays related to mitochondrial functions of three wild-type laboratory strains. In addition to the phenotypic variability among the wild-type strains, important differences have been observed among strains bearing identical mitochondrial tRNA mutations that could be related only to the different nuclear background of the cells. Results showed that strains exhibited an intrinsic variability in the severity of the effects of the mitochondrial mutations and that specific strains might be used preferentially to evaluate the phenotypic effect of mitochondrial mutations on carbon metabolism, stress responses, and mitochondrial DNA stability. In particular, while W303-1B and MCC123 strains should be used to study the effect of severe mitochondrial tRNA mutations, D273-10B/A1 strain is rather suitable for studying the effects of milder mutations.
在我们对线粒体缺陷的研究过程中,我们在酿酒酵母菌株中观察到了重要的表型变异,这表明更好地描述遗传变异性对于确定线粒体效率与不同核背景的存在之间的关系至关重要。在本论文中,我们通过比较三种野生型实验室菌株与线粒体功能相关的表型分析,扩展了对这种关系的研究。除了野生型菌株之间的表型变异性外,在携带相同线粒体tRNA突变的菌株中也观察到了重要差异,这些差异可能仅与细胞的不同核背景有关。结果表明,菌株在线粒体突变效应的严重程度上表现出内在变异性,并且特定菌株可能更适合用于评估线粒体突变对碳代谢、应激反应和线粒体DNA稳定性的表型效应。特别是,虽然应该使用W303 - 1B和MCC123菌株来研究严重线粒体tRNA突变的影响,但D273 - 10B/A1菌株更适合研究较轻突变的影响。